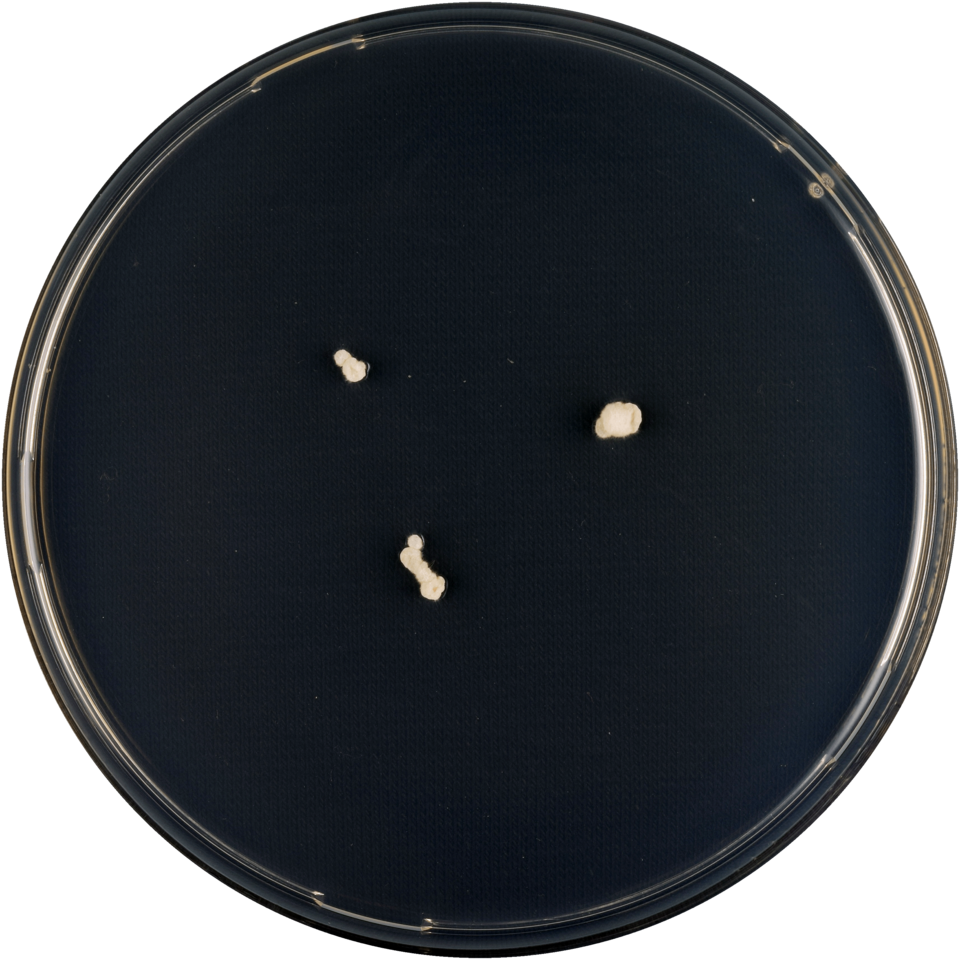
Geel Aspergillus conicus op voedingsbodem, cilindervormige conidiophoren.

Ontdek de kracht van Aspergillus conicus voor ongekende mogelijkheden. Optimaliseer uw projecten met deze hoogwaardige schimmelcultuur.
De Aspergillus conicus is een uniek product dat bekend staat om zijn veelzijdige toepassingen en voordelen. Deze schimmel behoort tot het geslacht Aspergillus en heeft een kegelvormige structuur. Met zijn opvallende uiterlijk en rijke geschiedenis van gebruik in verschillende industrieën, is de Aspergillus conicus een fascinerend organisme.
De Aspergillus conicus wordt vaak gebruikt in laboratoriumonderzoek en biotechnologische toepassingen vanwege zijn vermogen om enzymen te produceren die nuttig zijn bij verschillende processen. Daarnaast wordt het ook gebruikt in de voedingsindustrie voor het fermenteren van voedingsmiddelen en het produceren van smaakstoffen.
Deze unieke schimmel biedt een breed scala aan mogelijkheden voor onderzoekers, wetenschappers en professionals in verschillende vakgebieden. Met zijn unieke eigenschappen en potentieel voor innovatie, is de Aspergillus conicus een waardevolle toevoeging aan elke laboratoriumomgeving.
Ontdek de vele toepassingen en voordelen van de Aspergillus conicus en integreer dit fascinerende organisme in uw onderzoeks- of productieprocessen. Laat de Aspergillus conicus uw projecten inspireren en verbeteren met zijn unieke eigenschappen en veelzijdige mogelijkheden.